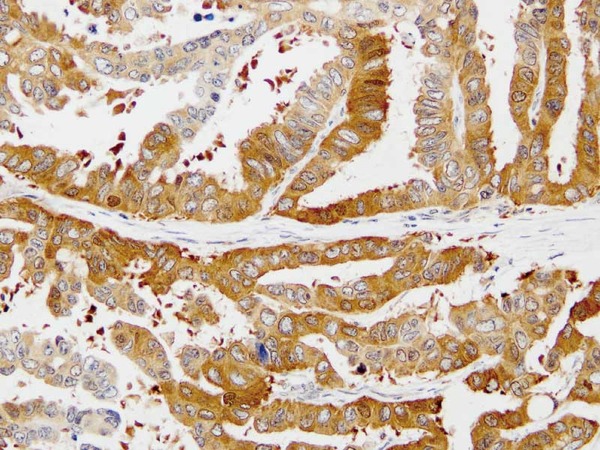

- HOME >
- For Researchers >
- Product Search >
- Search Result >
- #10411 Anti- DPD (ADPYDMAB) Mouse IgG MoAb
Product Search
#10411 Anti- DPD (ADPYDMAB) Mouse IgG MoAb
- Intended Use:
- Research reagents
- Application:
- WB, IHC
- Package Size1:
- 100 μg
- Package Size2:
- 10 μg
- Note on Application Abbreviations
- WB:Western Blotting
- IHC:Immunohistochemistry
※ The product indicated as "Research reagents" in the column Intended Use cannot be used
for diagnostic nor any medical purpose.
※ The datasheet listed on this page is sample only. Please refer to the datasheet
enclosed in the product purchased before use.
Product Overview
Product Overview
| Product Code | 10411 |
|---|---|
| Product Name | Anti- DPD (ADPYDMAB) Mouse IgG MoAb |
| Intended Use | Research reagents |
| Application | WB, IHC |
| Immunizing antigen | Human DPD protein |
| Source | Mouse-Mouse hybridoma |
| Clone Name | ADPYDMAB |
| Purification Method | Affinity purified with Protein A |
| Package Form | Lyophilized product in PBS containing 1 % BSA and 0.05 % NaN3 |
| Storage Condition | 2 - 8℃ |
| Poisonous and Deleterious Substances | Applicable |
| Cartagena | Not Applicable |
| Package Size 1 | 100 μg |
| Package Size 2 | 10 μg |
| Remarks1 | The commercial use of products without our permission is prohibited. Please make sure to contact us and obtain permission. |
Product Description
Product Description
Thymidylate synthase/TS (EC 2.1.1.45), Dihydropyrimidine degydrogenase/DPD (EC 1.3.1.2), Thymidene phosphorylase/TP (EC 2.4.2.4) and Orate phosphorybosyl transferase/OPRT (EC 2.4.2.10) are known as key enzymes related to nucleic-acid metabolism within the body.
These enzymes are also known to be related to activation, metabolism and catabolism of 5-FU (5-fluorouracil) which is a metabolic antagonist being widely used for solid cancers including digestive system cancer and breast cancer as an anticancer drug. And there are some reports regarding correlation between the enzymes and the effects of 5-FU-based anticancer drugs. Additionally, TS and DPD have been reported to be prognostification-related factors of individuals who suffer cancers.
As seen above, this antibody is useful for researches of nucleic acid and expression of those proteins in cancer tissues including effect prediction of 5-FU-based anticancer drugs and searching for prognostification factors.